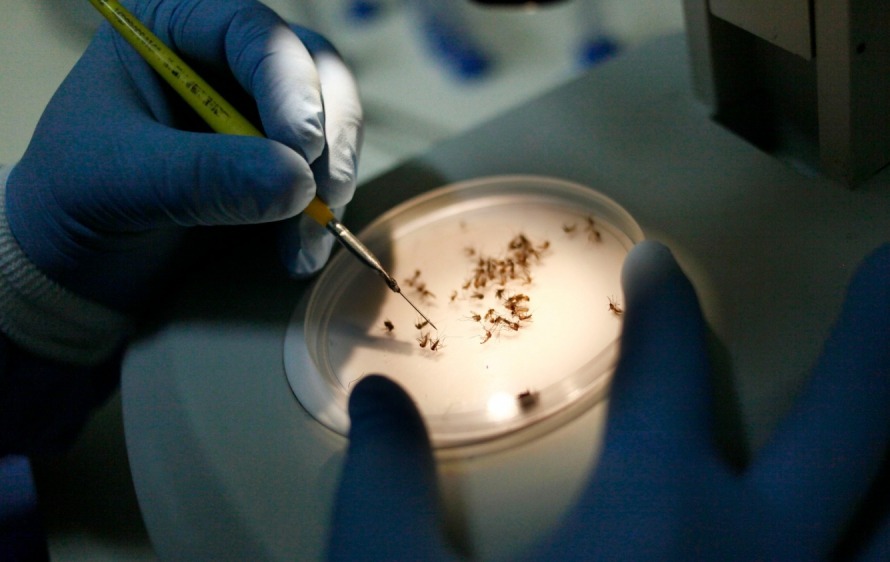

Rio
Governo do Rio decreta fim da epidemia de dengue no estado
A decisão, no entanto, não descarta a necessidade de continuar monitorando a doença
O Governador do Rio, Cláudio Castro, decretou, nesta terça-feira (11), o fim da epidemia de dengue em todo o estado. A decisão foi publicada no Diário Oficial e leva em consideração a queda no número de casos prováveis da doença, por nove semanas consecutivas, registrada pelo Centro de Inteligência em Saúde, da Secretaria Estadual de Saúde.
A decisão, no entanto, não descarta a necessidade de continuar monitorando a doença. Até o momento, o estado do Rio registrou 268.947 casos e 178 mortes por dengue
Crianças e adolescentes, com idades de 10 a 14 anos, grupo que apresenta maior risco de hospitalização pela doença, segundo o Ministério da Saúde, já podem se vacinar e contra a doença. A ordem de aplicação da vacina, realizada em duas doses, deve respeitar o intervalo de três meses, conforme a data da primeira dose aplicada.
O calendário e os locais de vacinação devem ser consultados no site da Secretaria Municipal de Saúde de cada cidade.






